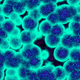
2631101 3712859

-
Walther Flemming cuidadosamente observa que las células animales se dividen en etapas y llama a al proceso Mitosis. De una manera Independiente Eduard Strasburger identifica un proceso similar de división celular en las células vegetales.
-
August Weismann identifica que las células sexuales deben estar divididas de manera diferente para terminar con sólo la mitad de cromosomas.
-
Los científicos descubren las mitocondrias, las centrales eléctricas de la célula. Estas pequeñas estructuras dentro de las células animales son responsables del metabolismo y de convertir los alimentos en sustancias químicas que las células pueden utilizar. Originalmente se pensaba que eran parte de la célula, los científicos ahora creen que son bacterias especializadas con su propio ADN.
-
William H. Bayliss y Ernest H. Starling nombran las hormonas y revelan su función como mensajeros químicos. El equipo describe específicamente la secretina, una sustancia que se libera en la sangre desde el duodeno (entre el estómago y el intestino delgado) que estimula la secreción del jugo pancreático digestivo en el intestino.
-
Funciona como una planta empaquetadora, modificando vesículas del retículo endoplasmático rugoso. El material nuevo de las membranas se forma en varias cisternas del aparato de Golgi. Dentro de las funciones que posee el aparato de Golgi se encuentran la glicosilación de proteínas, selección, destinación, glicosilación de lípidos, almacenamiento y distribución de lisosomas, al igual que los peroxisomas, que son vesículas de secreción de sustancias.
-
Hans Krebs identifica los pasos que la célula necesita para convertir los azúcares, grasas y proteínas en energía. También conocido como el ciclo del ácido cítrico, es una serie de reacciones químicas utilizando oxígeno como parte de la respiración celular. El ciclo contribuye a la descomposición de los carbohidratos, grasas y proteínas en dióxido de carbono y agua.
-
El descubrimiento de la proteína verde fluorescente por el doctor Osamu Shimomura en 1968 se produjo cuando estudiaba la capacidad de emitir luz verde de la medusa Aequorea victoria. Descubrió que están implicadas dos proteínas. Aequorin, que emite luz azul a través de un proceso de bioluminiscencia, y otra proteína capaz de absorber esta luz azul y emitir fotones de luz verde. A esta proteína se le denominó proteína verde fluorescente o GFP, del inglés Green Fluorescent Protein.
-
El citoesqueleto es un orgánulo y también es un entramado tridimensional de proteínas que provee soporte interno en las células, organiza las estructuras internas e interviene en los fenómenos de transporte, tráfico y división celular.Luego del descubrimiento del citoesqueleto a principios de los años 80 por el biólogo Keith Porter, el Dr. Donald Ingber consideró que, desde un punto de vista mecánico, la célula se comportaba de manera similar a estructuras arquitectónicas denominadas estructuras
-
Se inventa la técnica PCR (reacción en cadena de la polimerasa), que permite copiar genes específicos con gran rapidez. Es una técnica muy poderosa para producir millones de copias de una región específica de ADN, que permite analizarla tan rápido como se puede purificar una sustancia química. PCR ha sido el instrumento esencial en el desarrollo de técnicas de diagnóstico, medicina forense y la detección de genes asociados con errores innatos del metabolismo.
-
La apoptosis es una destrucción o muerte celular programada provocada por ella misma, con el fin de autocontrolar su desarrollo y crecimiento, está desencadenada por señales celulares controladas genéticamente. La apoptosis tiene una función muy importante en los organismos, pues hace posible la destrucción de las células dañadas, evitando la aparición de enfermedades como el cáncer, consecuencia de una replicación indiscriminada de una célula dañada.
Looking for a timeline maker?
Create timelines for projects, roadmaps, history, lessons, legal cases, and stories with Timetoast. Timetoast is a timeline maker for work, school, research, and stories.